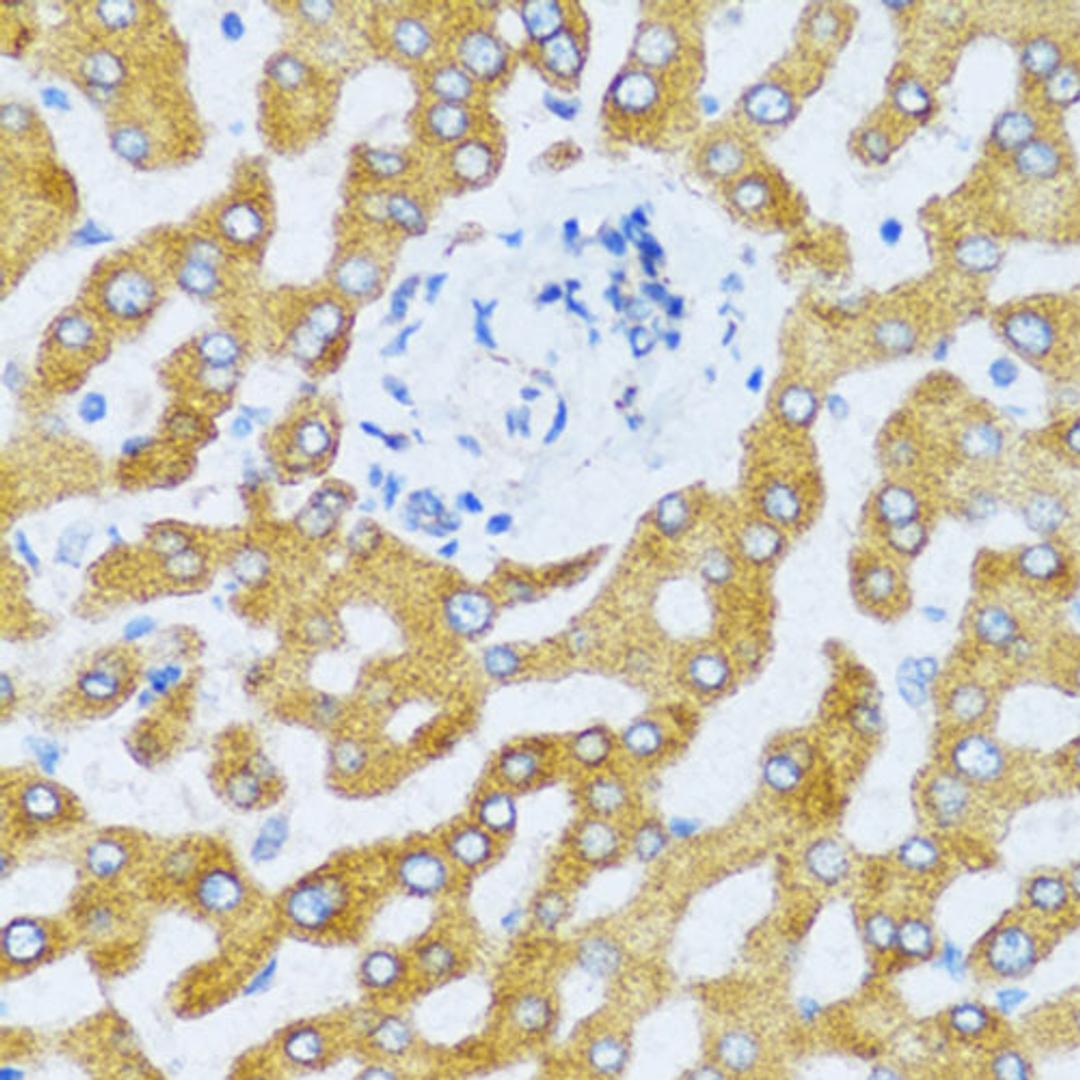
Immunohistochemistry - CCL25 antibody (A6543)

Product & ReviewsAntibodies
CCL25 Rabbit pAb
Product Details
- Cat. No.
- A6543
- Type
- Primary Antibody
- Clonality
- Polyclonal
- Host
- Rabbit

The supplier does not provide quotations for this antibody through SelectScience. You can search for similar antibodies in our Antibody Directory.
Description
This antimicrobial gene belongs to the subfamily of small cytokine CC genes. Cytokines are a family of secreted proteins involved in immunoregulatory and inflammatory processes. The CC cytokines are proteins characterized by two adjacent cysteines. The cytokine encoded by this gene displays chemotactic activity for dendritic cells, thymocytes, and activated macrophages but is inactive on peripheral blood lymphocytes and neutrophils. The product of this gene binds to chemokine receptor CCR9. Alternative splicing results in multiple transcript variants.
Biological Information
- Clonality: Polyclonal
- Host: Rabbit
- Reactivity: Human